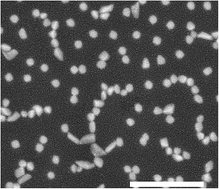

The development of supported catalysts based on simple procedures without waste products and time-consuming steps is highly desirable. In this paper, self-supported nickel-based nanoparticles were obtained at the surface of the germanophosphate glasses by bottom-up process and evaluated as potential catalysts for the benzyl alcohol oxidation and bis(indolyl)methanes synthesis. A classical melt-quenching technique was used for preparing the nickel-doped germanophosphate glasses, followed by annealing under a hydrogen atmosphere at 400 °C for two different times. The approach enabled the synthesis of self-supported nanoparticles as a homogeneous film, covering the glass surface. The physical and chemical properties of synthesized glasses were characterized by UV-vis and Raman spectroscopies and thermal analysis. Scanning electron microscopy (SEM) and X-ray photoelectron spectroscopy (XPS) were performed to monitor the growth process, morphology and chemical bonding structure of the nanoparticles surface.